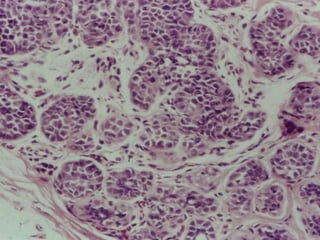
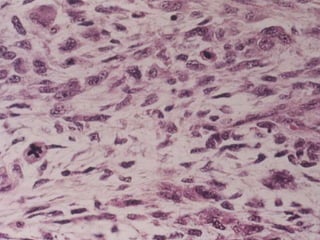
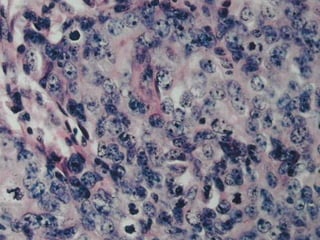

O documento discute vários tópicos relacionados à mama, incluindo: 1) histologia normal e alterações, como distúrbios do desenvolvimento, processos inflamatórios e alterações fibrocísticas; 2) manifestações clínicas usuais; e 3) neoplasias mamárias benignas e malignas, como carcinomas ductal e lobular.













![MAMA Manifestações
clínicas em 372 mulheres
durante 539
atendimentos, ao longo
de 10 anos em
ambulatório. Algumas,
mais de um sintoma ao
atendimento. Biópsias em
10%. [Kumar. Pathologic
Basis of Disease, 7ed,
Elsevier, 2005]](https://image.slidesharecdn.com/patologiamamria-220914225257-c8b76eb0/85/PATOLOGIA-MAMARIA-ppt-14-320.jpg)